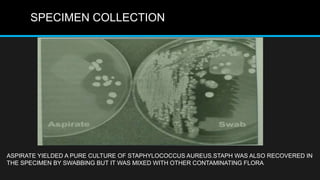
SPECIMEN COLLECTION
ASPIRATE YIELDED A PURE CULTURE OF STAPHYLOCOCCUS AUREUS.STAPH WAS ALSO RECOVERED IN
THE SPECIMEN BY SWABBING BUT IT WAS MIXED WITH OTHER CONTAMINATING FLORA

This document discusses quality control in microbiology. It covers various aspects of quality control including the pre-analytic, analytic and post-analytic phases of diagnostic testing. In the pre-analytic phase, it discusses proper specimen collection, transport and processing. The analytic phase covers microscopic examination, culture processing, identification and antimicrobial susceptibility testing. It also discusses quality control of equipment, reagents and culture media. The post-analytic phase involves reporting of results and interaction with epidemiologists. Maintaining accurate records and samples is also emphasized.